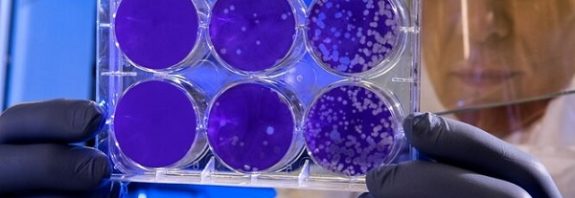
Bilim İnsanları Virüsün Bir Kişiye Saldırdığı Anı Videoya Kaydetti

Bilim İnsanları Virüsün Bir Kişiye Saldırdığı Anı Videoya Kaydetti
Bilim İnsanları Virüsün Bir Kişiye Saldırdığı Anı Videoya Kaydetti Araştırmacılar, sağlıklı bir hücreyi ele geçirmeden hemen önce virüslerin hareketinin ilk … Bilim İnsanları Virüsün Bir Kişiye Saldırdığı Anı Videoya Kaydetti okumayı sürdür
1 Yorum